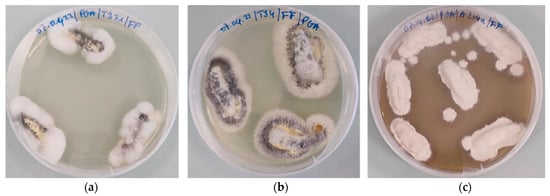

Abstract
The fall armyworm, Spodoptera frugiperda (Lepidoptera: Noctuidae), is a polyphagous pest highly damaging to maize and other food crops in Africa, particularly in Côte d’Ivoire. Chemical pesticides not only have often proved to be unsuccessful, but cause adverse effects on the environment and human health; therefore, entomopathogenic fungi could represent an alternative biocontrol solution. Against this background, fungi were isolated from soil samples collected in maize fields in three regions of Côte d’Ivoire, by the methods of soil dilution and baiting with Galleria mellonella. The resulting 86 fungal isolates were phenotypically and genetically identified. The pathogenicity of seven isolates of Metarhizium spp., three isolates of Beauveria bassiana and two isolates of Trichoderma sp. was evaluated on fifth instar larvae (L5) of G. mellonella. Larval mortality rates and the median lethal time (LT50) were determined seven days after inoculation for each of these selected isolates. The median lethal concentration (LC50) was determined for a selection of isolates. Beauveria bassiana isolate A214b was the most effective, causing 100% mortality, with an LT50 of 2.64 days and an LC50 of 1.12 × 104 conidia mL−1. Two other promising isolates, A211 and A214a, belonging to B. bassiana, caused 100% mortality with LT50 values of 3.44 and 4.04 days, respectively. Mortality caused by Metarhizium isolates varied from 65.38% to 100%, with Metarhizium anisopliae isolate T331 causing 100% mortality with an LT50 of 3.08 days at an LC50 of 3.33 × 104 conidia mL−1. Trichoderma sp. isolates were the least pathogenic ones. Beauveria bassiana and Metarhizium isolates showed to be virulent against the model Lepidopteran G. mellonella and will be tested on S. frugiperda.
1. Introduction
The fall armyworm or American corn moth (Spodoptera frugiperda J.E. Smith) is native to tropical and subtropical regions of America. This pest feeds on the leaves and stems of more than 353 plant species [1]. It prefers maize, but is also known as a pest on other crops of economic importance, including cotton, rice, soy, sugar cane, beets, peanut, pumpkin, cabbage, spinach, beans, sorghum, wheat and tomato [2,3]. Moreover, S. frugiperda has a very high reproductive rate, considering that a female can lay up to 1000 eggs during its life [4].
This insect attacks all aerial parts of maize, mostly feeding on leaves. They also sometimes cut the stems of seedlings [5]. On young maize plants, whorl damage may affect growing points, preventing cobs’ formation. In severe infestations, plants are completely stripped of their leaves. Feeding deep into the leaf whorl can also destroy developing panicles [1].
In Latin America, this pest has caused production losses of up to 90% [6]. In West Africa it was first reported in 2016 in Nigeria, Benin and Togo, and has subsequently spread to other countries including Côte d’Ivoire [7,8,9]. In August 2016, more than 30,000 ha of maize were destroyed in the regions of northern Benin [5,7].
Chemical control used against this pest proved to be ineffective. In addition, the frequent use of these pesticides causes problems such as the development of resistance in the pest population [10], the reduction of the populations of natural enemies and the pollution of the environment [10]. In view of these disadvantages, it is necessary to find alternative control methods that are effective and respectful of people and the environment. There are currently between 700 and 800 species of fungi listed as entomopathogenic. Most of these fungi belong to the Zygomycetes, Ascomycetes and Chytridiomycetes families [11]. Some entomopathogenic Ascomycetes belonging to the Hypocreales family have a wide spectrum of actions and can infect several species of insects at different stages, thus causing epizootics under natural conditions [12]. Species of the genera Beauveria, Metarhizium, Hirsutella, Erynia, Verticillium, Entomophtora, Entomophaga and Isaria have already provided efficient fungal isolates, which have been developed as phytosanitary products and commonly used against insect pests in the world. Several isolates belonging to three different genera (Metarhizium, Beauveria and Isaria) were tested in vitro to determine their efficacy on second instar larvae of S. frugiperda [3]. However, there are also fungal genera such as Trichoderma or Penicillium, which are less studied from an entomopathogenic point of view, but might be considered as well [13,14].
Despite the interest aroused by the use of entomopathogenic fungi, very few studies have been carried out in general on these fungi in Western Africa and particularly in Côte d’Ivoire. This study was carried out to generate data and enrich knowledge in this domain. To achieve this, the presence of entomopathogenic fungi in some maize fields in Côte d’Ivoire was assessed. In addition, a pre-screening was carried out on Galleria mellonella, in a Swiss laboratory, where it is not allowed to import S. frugiperda. Galleria mellonella is easily available and lives long enough to perform such tests. It also seems to be a good insect model for observing the virulence of a microorganism against Lepidoptera [15]. The next step of this study will be to test these fungi, in greenhouses and in the field, on S. frugiperda larvae on maize, in Côte d’Ivoire.
2. Materials and Methods
2.1. Sample Collection
The collection of soil samples was made in six localities of maize production in three regions of Côte d’Ivoire (Agnibilékrou; Ferkessedougou; Gagnoa; Korhogo; Ouangolodougou and Tiassalé). In each locality, 5 fields were prospected and 20 samples of 100 g of soil were taken, using a trowel, from the superficial layer (5–10 cm depth) at the foot of randomly selected maize plants according to the method of Thaochan and Sausa-Ard [16]. To avoid contamination from one sampling point to another, the sampling trowel was cleaned with sodium hypochlorite 5% between samplings. Hands were also disinfected with a hydroalcoholic solution (ethanol 70% v/v). Soil samples were kept in transparent plastic bags with GPS coordinates of the sampling locations (see Table S1). These samples were brought back to the laboratory and those from the same locality were mixed together to form a composite sample.
2.2. Isolation of Fungi
Two methods were used for the isolation of fungi, the soil dilution method [17] and the baiting method, using the Lepidoteran G. mellonella as a bait, developed by Zimmermann [18] and adapted by Laurent et al. [19].
Serial soil dilution suspensions were prepared from 10−1 to 10−7 starting from a stock solution obtained after dissolving 1 g of soil in 9 mL of distilled water. Then, 100 μL of the dilutions from 10−2 to 10−7 were spread on potato glucose agar (PGA, Carl Roth, Arlesheim, Switzerland) in Petri plates in three replicates before all Petri dishes were sealed and incubated at 25 °C in the laboratory. Two days after inoculation, the fungal colonies that appeared were subcultured separately on new PGA dishes in order to obtain pure cultures.
As for the insect baiting method, the composite soil samples were each subdivided into three subsamples of 50 g. Each subsample was placed into sterile 500 mL plastic boxes (Sac O2 Microbox, Deinze, Belgium) and moistened with 1 mL sterile distilled water; five fifth-instar (L5) larvae of G. mellonella were then added in each box. Two control boxes only containing five larvae were also set in parallel. Then, all trays were stored in an incubator Firlabo Bio Concept (Froilabo, Meyzieu, France) at room temperature (25 °C) in the dark. The trays were turned over every day to assure maximum soil–larvae contact. Then, a daily control of the larvae was carried out for three weeks in order to remove the dead larvae from the soil.
Dead larvae were disinfected by dipping in 70% ethanol for 10 s, then in 1% sodium hypochlorite for 3 min, followed by rinsing twice in sterile distilled water for 1 min. After disinfection, each larva was placed into a 9 cm diameter Petri dish on a 9 cm diameter cellulose filter (Rotilabo®, Carl Roth), moistened with 1 mL distilled water. Petri dishes were incubated at 25 °C in the dark. The larvae on which fungal sporulation occurred were then removed with sterile forceps and individually deposited on Petri dishes containing PGA amended with 200 mg/L of ampicillin (Carl Roth) 200 mg/L chlortetracycline (Carl Roth), which were then sealed with ParafilmTM and incubated at 25 °C [19]. Several subcultures were sometimes necessary to yield pure fungal cultures.
2.3. Molecular Identification of Isolated Strains
The collected isolates were first sorted and classified by morphotypes; then one or two isolates were selected for species identification and cultured in potato glucose broth (PGB; Carl Roth) for 4 to 7 days, with gentle shaking. DNA was extracted following a published protocol [20]. The PCR amplification of the rDNA internal transcribed spacers (ITS) region was carried out by using the primer pair ITS4/ITS5 [21], in a reaction volume of 25 μL. The reaction mixture was prepared with 16.6 μL of ultrapure water, 5 μL from My Taq Reaction Buffer (Bioline GmbH, Germany), 2.5 µL Primer ITS4/ITS5, 0.4 µL My Taq HS DNA polymerase (1 unit/µL; Bioline GmbH), and 0.5 µL of DNA (50 ng/µL). The amplification was carried out in a BIOMETRA thermocycler (Labgene Scientific SA, Châtel St-Denis, Switzerland) under the following conditions: initial denaturation 95 °C for 1 min; followed by 34 cycle of denaturation 95 °C for 15 s; annealing 56 °C for 10 s; elongation 72 °C for 12 s terminated at 4 °C. Following amplification, the PCR products were submitted to electrophoresis on a 1% agarose gel in TBE buffer 1X (Carl Roth) for 35 min under an electrical voltage of 135 mV and visualized under UV with the U: GENIUS3 gel reader (Syngene, Cambridge, UK). Successfully amplified PCR were purified with the kit Wizard® SV Gel and PCR Clean-Up System (Promega AG, Dübendorf, Switzerland) and sent to Microsynth AG (Balgach, Switzerland) for Sanger Sequencing. Sequences were edited with FinchTV v. 1.4 (Geospiza Inc., Denver, CO, USA) and identified by searching the NCBI nucleotide database using BLAST (https://blast.ncbi.nlm.nih.gov/Blast.cgi, accessed on 28 February 2022).
2.4. Assessing Pathogenicity of Isolates on Galleria mellonella
Conidia were applied to the larvae following the immersion method [22,23]. A conidial suspension at a concentration of 5 × 106 conidia mL−1 was prepared by diluting a stock conidial suspension (5 × 108 conidia mL−1) in a solution of 10% phosphate buffered saline (PBS, Carl Roth) and 0.03% Tween 20 (Carl Roth) in sterile distilled water. Then, 30 L5 larvae of G. mellonella were soaked in 100 mL of the prepared conidial suspension for 10 s. Thirty other larvae representing the controls were also soaked in 100 mL of the diluting solution. For each modality, 10 treated larvae were placed in 500 mL plastic trays (Sac O2 Microbox) and incubated in a climatic chamber (Percival Scientific, Iowa, USA) at 25 °C, 60% relative humidity in the dark for 7 days. No food was provided because the L5 stage of G. mellonella is the last larval stage before pupation. Larval mortality was monitored daily. Koch’s postulates were verified by performing re-isolation of the entomopathogenic strains from the dead larvae. For this purpose, remains of G. mellonella were sterilized and incubated according to the baiting method. Three isolates (A214b, T331 and T34), identified as best performers in the first test, were selected for determination of LC50. At this end, conidia suspensions with concentrations of 5 × 103, 5 × 104, 5 × 105 and 5 × 106 conidia mL−1 were prepared and applied to the larvae as described previously.
2.5. Statistical Analysis
The percentage of larval mortality was calculated using the formula of Abbott [24]. Data were analyzed using STATISTICA 7.1 software. An analysis of variance with one classification criterion (ANOVA1) made it possible to compare the average mortality rates of the larvae according to the fungal isolates. In the event of a significant difference at the 5% level, Tukey’s HSD test was used to determine the homogeneous groups. In addition, the mean lethal time (LT50) and lethal concentration (LC50) were determined using the log/probit methods of analysis [25].
3. Results
3.1. Fungi Isolated
A total of 86 fungi were isolated (Figure 1): the soil dilution method yielded 27 isolates from 13 genera (Table S2) and 59 isolates belonging to 9 genera were obtained with the baiting method (Table S3). From the baiting method, only one isolate representative of dissimilar individual morphotypes was used for ITS sequencing. The resulting sequences of forty-four isolates were registered in the NCBI Nucleotide database (https://www.ncbi.nlm.nih.gov/nuccore/; accessed on 2 April 2022) under the accessions numbers to ON121940 to ON121983 (Table S4). Figure 2a,b shows the distribution of isolated fungi from both methods.

Figure 1.
Examples of fungal morphotypes isolated: (a) M. anisopliae isolate T35; (b) Metarhizium sp. isolate T313; (c) Trichoderma harzianum isolate A331; (d) B. bassiana isolate A214a; (e) Fusarium oxy-sporum isolate T251.

Figure 2.
Isolation rates of fungi according to genus and method of isolation. (a) Fungi isolated by the baiting method; (b) fungi isolated by the soil dilution method.
Fourteen isolates are potentially entomopathogenic according to the literature (Table 1). Twelve of these strains were obtained from the baiting method; that is, five isolates of Metarhizium sp., two isolates of M. anisopliae, three isolates of B. bassiana and two isolates of Trichoderma sp. The other two isolates of Trichoderma sp. were obtained through the soil dilution method.

Table 1.
Fungal strains belonging to potentially entomopathogenic species used for pathogenicity testing on Galleria mellonella.
3.2. Pathogenicity of Isolates on Galleria mellonella Larvae
The results obtained showed that all fungi tested in this study except Trichoderma sp. strains were pathogenic against G. mellonella. The first dead larvae were observed 2 days after treatment for all isolates of B. bassiana and for Metarhizium spp. isolates (T331, T34, T35). Larval mortality rates varied from 3.33% to 100%. Beauveria bassiana isolates (A211, A214a, A214b) and M. anisopliae isolate T331 induced 100% mortality of G. mellonella larvae. Metarhizium anisopliae isolate T35 and Metarhizium sp. isolates (T34, T121, T313, T141, and T132) caused 93.33%, 90%; 90%; 86.67%; 80% and 70% mortality, respectively. The mortality rates were 16.33% for the T. longibrachiatum isolate Ko4 and 3.33% for T. asperellum isolate Ou5 (Figure 3). Statistical analysis showed significant differences in mortality rates between Metarhizium spp. and B. bassiana isolates compared to controls. However, no differences were observed between mortality rates of Metarhizium spp. and B. bassiana isolates. For Trichoderma isolates, mortality rates did not significantly differ from the control (F = 17.39; DL = 10; p ˂ 0.000).

Figure 3.
Mortality rate of G. mellonella larvae according to isolates, 7 days after inoculation with 5 × 106 conidia mL−1.
Koch’s postulates showed that all tested fungi were responsible for larval death (Figure 4), with the exception of Trichoderma isolates (Table 2).
Figure 4.
Fungi re-isolation from cadavers on PGA. (a) M. anisopliae isolate T331; (b) Metarhizium sp. isolate T34; (c) B. bassiana isolate A214a.

Table 2.
Re-isolation rate after verification of Koch’s postulate according isolates.
Regarding the mean lethal time (LT50), B. bassiana isolate A214b quickly developed its pathogenicity, with an LT50 of 2.64 days followed by M. anisopliae isolate T331 and B. bassiana isolate A211. The LT50 values of these latter were respectively 3.08 days and 3.44 days. The LT50 of B. bassiana isolate A214a and Metarhizium sp. isolates T34, T35, T121, T132, T141 and T313 were respectively 4.01, 3.55, 5.70, 3.56, 6.41, 5.20 and 6.61 days. No Trichoderma sp. used in this study yielded a 50% mortality of the G. mellonella population. The LC50 results showed that the rate of mortality increased with the concentration. The lowest mortality percentage (10%) was recorded for larvae inoculated with Metarhizium sp. isolate T34 at a concentration of 5 × 103 conidia mL−1. This rate increased when larvae were exposed to concentrations 5 × 104, 5 × 105 and 5 × 106 conidia mL−1, with mortality rates of 25%, 71%, 42% and 88.57%, respectively. LC50 of 1.12 × 104 and 3.47 × 104 conidia mL−1 were obtained for isolates A214b and T331. Isolate T34 had an LC50 of 2.19 × 105 conidia mL−1 (Table 3).

Table 3.
Mean lethal concentration (LC50) and lethal time (LT50) according the best isolates by morphotype.
4. Discussion
This study enabled us to isolate a wide range of fungi, regardless of the method used. The method of isolation by dilution made it possible to isolate a greater fungal diversity. The majority of these fungi were saprophytic with the genera Fusarium and Aspergillus in large numbers, unlike the baiting method. These results corroborate those of Sengul and Sera [26], who isolated fungi with a similar soil dilution method. In their works, the genera Penicillium, Aspergillus, Fusarium and Trichoderma were the most abundant. In addition, the genera Aspergillus, Fusarium and Paecilomyces were isolated with the same method by Ibrahim et al. [27]. Although the baiting method allowed the isolation of fewer genera, it was way more effective in terms of the isolation of entomopathogenic fungi. However, the number of Metarhizium strains isolated was far greater than for Beauveria bassiana. Similar results were obtained by Correa et al. [28]. Our results are also similar to those of Baydar et al. [29], who isolated fungi belonging to the genera Metarhizium sp., Beauveria sp., Fusarium spp., Aspergillus spp., Penicillium spp. and Paecilomyces lilacinus, from Turkish soils using the baiting method. The difference between isolation methods could rely on the fact that the dilution method would promote the rapid development of saprophytic fungi on the PGA medium, which could prevent the development of other fungi. In addition, the amount of soil used in dilution would reduce the chance to isolate useful fungi, considering the small quantity of soil (1 g) used for the dilution. The difference could also be explained by the sensitivity of G. mellonella to entomopathogenic fungi. This baiting method would therefore be the best way to select for entomopathogenic fungi. According to Meyling [30], who compared different methods used for isolating entomopathogenic fungi, the dilution method allows opportunistic fungi to proliferate on culture media, whereas the baiting method with G. mellonella is a very sensitive detection method for selectively isolating entomopathogenic fungi.
Fungi M. anisopliae and B. bassiana have been effective on G. mellonella larvae. Similar results were also obtained by Saleh et al. [31], who obtained mortalities of 100% and 98.4%, respectively, with B. bassiana and M. anisopliae. The same rate of mortality (100%) was obtained [32] on G. mellonella larvae inoculated with M. anisopliae isolate ARSEF 5520 at concentration of 3.6 × 106 conidia mL−1. Entomopathogenic fungi B. bassiana and Metarhizium sp. are capable of infecting different species belonging to the order Lepidoptera. Indeed, efficacy tests on second instar larvae of S. frugiperda using the B. bassiana isolate BCMU6 showed a 91.67% mortality rate 12 days after inoculation at a concentration of 108 conidia mL−1 [33]. Similar results were obtained with M. anisopliae and B. bassiana on fourth instar larvae of Spodoptera litura. Mortality rates of 100% were achieved with two B. bassiana isolates (TA-4; KSH-2) and two M. anisopliae isolates (KSH-8, KZ-2) [34].
In the present study, the verification of Koch’s postulates showed that larval mortality was caused by the strains tested, with the exception Trichoderma isolates, which could not be recovered from dead larvae. This could be explained by the fact that Trichoderma sp. isolates would not be responsible for the death of larvae. The shortest LT50 of 2.64 days was obtained with B. bassiana strain A214b. The isolates M. anisopliae T331 and B. bassiana A211 had an LT50 of 3.08 days and 3.44 days, respectively. These results are similar to those of Oreste et al. [35], who obtained mean survival times (MST) of 2.2 and 2.3 days using two isolates of B. bassiana AL1 and ALB55. The LT50 and LC50 values showed that some fungi, in particular B. bassiana isolate A214b, M. anisopliae isolate T331 and Metarhizium sp. isolate T34, are highly virulent against G. mellonella larvae. These results could be explained by the viability/concentration of the conidia and the action time of the fungi. According to several authors [25,36], the degree of virulence of entomopathogenic fungi is closely related to the viability of conidia.
5. Conclusions
This study isolated entomopathogenic fungi from soil samples collected in maize fields in Côte d’Ivoire. The method of isolation by baiting proved to be the most effective.
All the tested fungi were pathogenic to G. mellonella with the exception of two Trichoderma isolates, which caused very low mortality rates. Isolated B. bassiana, M. anisopliae and Metarhizium sp. caused larval mortality rates greater than 50%, and up to 100%. The determination of their LT50 and LC50 has shown that these fungi have insecticidal potential and virulence against G. mellonella. These fungi will therefore be assayed against S. frugiperda in vitro, in greenhouse and field tests, with the hope to soon deliver a biological control agent against the fall armyworm.
Supplementary Materials
The following supporting information can be downloaded at: https://www.mdpi.com/article/10.3390/microorganisms11082104/s1. Table S1: Sampled localities, GPS coordinates and samples constitution; Table S2: Fungal isolates obtained by the dilution method; Table S3: Fungal isolates obtained by the baiting method; Table S4: Genetic identifications of isolates from both methods.
Author Contributions
Conceptualization, F.F., C.D. and F.L.; methodology, F.F., C.D. and F.L.; validation, C.D. and F.L.; formal analysis, F.F. and C.D.; investigation, F.F. and C.D.; resources, F.L.; data curation, F.F., C.D. and F.L.; writing—original draft preparation, F.F.; writing—review and editing, F.F., C.D., A.P.K. and F.L.; supervision, A.P.K. and F.L.; project administration, F.L.; funding acquisition, F.L. All authors have read and agreed to the published version of the manuscript.
Funding
These works were funded by the Swiss Confederation through an Excellence award to Fatoumatou Fofana (Grant No 2021.55) and the Research Strategic Fund of the HES-SO University of Applied Sciences and Arts Western Switzerland.
Institutional Review Board Statement
Not applicable.
Informed Consent Statement
Not applicable.
Data Availability Statement
Not applicable.
Acknowledgments
Special thanks are extended to Romain Chablais, Julien Crovadore, Yannick Barth, Lucas Arminjon and Hendrick Vermeulen for their helpful advice.
Conflicts of Interest
The authors declare no conflict of interest.
References
- CABI. Scientists Discover New Crop-Destroying Armyworm Is Now “Spreading Rapidly” in Africa; CABI: Wallingford, UK, 2017; Available online: http://www.cabi.org/news-and-media/2017/scientistsdiscover-new-crop-destroying-armyworm-is-now-spreading-rapidly-in-africa (accessed on 10 September 2021).
- Montezano, D.G.; Specht, A.; Sosa-Gómez, D.R.; Roque-Specht, V.F.; Sousa-Silva, J.C.; Paula-Moraes, S.V.; Peterson, J.A.; Hunt, T.E. Host plants of Spodoptera frugiperda (Lepidoptera: Noctuidae) in the Americas. Afr. Entomol. 2018, 26, 286–301. [Google Scholar] [CrossRef]
- Prasanna, B.M.; Huessing, J.E.; Eddy; Peschke, V.M. Fall Armyworm in Africa: A Guide for Integrated Pest Management; First Edition Mexico; USAID: Washington, DC, USA; CIMMYT: El Batán, Mexico, 2018; 120p.
- Maiga, I. Note d’Informations Générales sur la Noctuelle du Maïs Spodoptera frugiperda J.E. Smith. In Un Ravageur Redoutable et très Polyphage à Surveiller; Centre Régional AGRHYMET/CILSS: Niamey, Niger, 2017; 16p. [Google Scholar]
- CILSS. La Chenille D’automne Spodoptera frugiperda, Nouveau Ravageur du Maïs en Afrique de l’Ouest, a Atteint le Niger; Bulletin Spécial; Centre Régional AGRHYMET: Niamey, Niger, 2017; 7p. [Google Scholar]
- Ruiz-Nájera, R.E.; Ruiz-Estudillo, R.A.; Sánchez-Yáñez, J.M.; Molina-Ochoa, J.; Skoda, S.R.; Coutiño-Ruiz, R.; Pinto-Ruiz, R.; Guevara-Hernández, F.; Foster, J.E. Occurrence of entomopathologic fungi and parasitic nematodes on Spodoptera frugiperda (Lepidoptera: Noctuidae) larvae collected in central Chiapes. Fla. Entomol. 2013, 96, 498–503. [Google Scholar] [CrossRef]
- Hama, A.; Adamou, H.; Adamou, B.; Salifou, A.; Delams, P. Alerte: Spodoptera frugiperda, une Nouvelle Chenille Ravageur de Maïs; Note d’Information/Traitements Phytosanitaires et Ravageurs; Réseau National des Chambres d’Agriculture du Niger: Niamey, Niger, 2016; 3p. [Google Scholar]
- Tizié, Y.G.; N’Guessan, C. Atelier de Renforcement des Capacités des Etats Membres de la CEDEAO Pour Lutter Contre L’invasion de Spodoptera frugiperda en Afrique de L’ouest; Compte-Rendu d’AtelierL: Bordeaux, France, 2017; 35p. [Google Scholar]
- Goergen, G.; Kumar, P.L.; Sankung, S.B.; Togola, A.; Tamò, M. First report of outbreaks of Fall Armyworm Spodoptera frugiperda (J E Smith) (Lepidoptera, Noctuidae), a new alien invasive pest in West and Central Africa. PLoS ONE 2016, 11, e0165632. [Google Scholar] [CrossRef] [PubMed]
- Yu, S.J.; Nguyen, S.N.; Abo-Elgharg, E. Biochemical characteristics of insecticide resistance in the fall armyworm, Spodoptera frugiperda (J.E. Smith). Pestic. Biochem. Physiol. 2003, 77, 1–11. [Google Scholar] [CrossRef]
- Bawin, T.; Seye, F.; Boukraa, S.; Zimmer, J.Y.; Delvigne, F.; Francis, F. La lutte contre les moustiques (Diptera: Culicidae): Diversité des approches et application du contrôle biologique. Can. Entomol. 2015, 147, 476–500. [Google Scholar] [CrossRef]
- Alves, S.B.; Lopes, R.B.; Vieira, S.A.; Tamai, M.A. Fungos entomopatogênicos usados no controle de pragas na América Latina. In Controle Microbiano de Pragas na América Latina: Avanços e Desafios; Alves, S.B., Ed.; FEALQ: Piracicaba, Brazil, 2008; pp. 69–110. [Google Scholar]
- Islam, M.S.; Subbiah, V.K.; Siddiquee, S. Efficacy of Entomopathogenic Trichoderma Isolates against Sugarcane Woolly Aphid, Ceratovacuna lanigera Zehntner (Hemiptera: Aphididae). Horticulturae 2022, 8, 2. [Google Scholar] [CrossRef]
- Poveda, J. Trichoderma as biocontrol agent against pests: New uses for a mycoparasite. Biol. Control 2021, 159, 104634. [Google Scholar] [CrossRef]
- Demirci, S.N.Ş.; Altuntaş, H. Entomopathogenic potential of Purpureocillium lilacinum against the model insect Galleria mellonella (Lepidoptera: Pyralidae). Environ. Exp. Biol. 2019, 17, 71–74. [Google Scholar]
- Thaochan, N.; Sausa-Ard, W. Occurrence and effectiveness of indigenous Metarhizium anisopliae against adults Zeugodacus cucurbitae (Coquillett) (Diptera: Tephritidae) in Southern Thailand. Songklanakarin. J. Sci. Technol. 2017, 39, 325–334. [Google Scholar]
- Davet, P.; Rouxel, F. Detection and Isolation of Fungi from the Soil; Edition INRA: Paris, France, 1997; p. 194. [Google Scholar]
- Zimmerman, G. The Galleria bait method’ for detection of entomopathogenic fungi in soil. J. Appl. Entomol. 1986, 102, 213–215. [Google Scholar] [CrossRef]
- Laurent, L.; Crovadore, J.; Deneux, P.; Cochard, B.; Ravat, P.C.; Chablais, R.; Bovigny, P.Y.; Lefort, F. New strains of entomopathogenic fungi isolated from organic orchards in Geneva. Commun. Agric. Appl. Biol. 2017, 82, 207–212. [Google Scholar]
- Ripoll, J.; Bon, M.C.; Jones, W. Optimization of genomic DNA extraction from yellow nightshade (Solanum elaeagnifolium Cav.), an invasive plant in cultivated areas in the Mediterranean region. Biotechnol. Agron. Soc. Environ. 2011, 15, 95–100. [Google Scholar]
- White, T.J.; Bruns, T.D.; Lee, S.B.; Taylor, J.W. Amplification and Direct Sequencing of Fungal Ribosomal RNA Genes for Phylogenetics. In PCR Protocols: A Guide to Methods and Applications; Innis, M.A., Gelfand, D.H., Sninsky, J.J., White, T.J., Eds.; Academic Press: New York, NY, USA, 1990; pp. 315–322. [Google Scholar]
- Sohrabi, F.; Jamali, F.; Morammazi, S.; Saber, M.; Kamita, S.G. Evaluation of the compatibility of entomopathogenic fungi and two botanical insecticides tondexir and palizin for controlling Galleria mellonella L. (Lepidoptera: Pyralidae). Crop Prot. 2019, 117, 20–25. [Google Scholar] [CrossRef]
- Gołębiowski, M.; Bojke, A.; Tkaczuk, C. Effects of the entomopathogenic fungi Metarhizium robertsii, Metarhizium flavoviride, and Isaria fumosorosea on the lipid composition of Galleria mellonella larvae. Mycologia 2021, 113, 525–535. [Google Scholar] [CrossRef]
- Abbott, W.S. A method of computing the effectiveness of an insecticide. J. Econ. Entomol. 1925, 18, 265–267. [Google Scholar] [CrossRef]
- Sabbahi, R.; Merzouki, A.; Guertin, C. Efficacy of Beauveria bassiana (Bals.) Vuill. Against the tarnished plant bug, Lygus lineolaris L., in strawberries. J. Appl. Entomol. 2008, 132, 124–134. [Google Scholar] [CrossRef]
- Sengul, A.K.; Serdar, U. Isolation, identification and seasonal distribution of soilborne fungi in tea growing areas of Iyidere-Ikizdere vicinity (Rize-Turkey). J. Basic Microbiol. 2006, 46, 208–218. [Google Scholar]
- Ibrahim, A.A.; Mohamed, H.F.; El-Naggar, S.E.M.; Swelim, M.A.; Elkhawaga, O.E. Isolation and selection of entomopathogenic fungi as biocontrol agent against the Greater Wax Moth, Galleria mellonella L. (Lepidoptera: Pyralidae). Egypt. J. Biol. Pest Control 2016, 26, 249–253. [Google Scholar]
- Correa, T.A.; Santos, F.S.; Camargo, M.G.; Quinelato, S.; Bittencourt, V.R.E.P.; Golo, P.S. Comparison of methods for isolating entomopathogenic fungi from soil samples. JOVE 2022, 179, e63353. [Google Scholar]
- Meyling, N.V. Methods for Isolation of Entomopathogenic Fungi from the Soil Environment, Laboratory Manual. Deliverable 5.1, VegQure, DARCOF III: Research in Organic Food and Farming (FØJO III). 2007. Available online: https://orgprints.org/id/eprint/11200/ (accessed on 1 April 2022).
- Baydar, R.; Güven, Ö.; Karaca, I. Occurrence of Entomopathogenic Fungi in Agriculture Soils Isparta Provence in Turkey and their Pathogenicity to Galleria mellonella (L.) (Lepidoptera: Pyralidae) larvae. Egypt. J. Biol. Pest Control 2016, 26, 323–327. [Google Scholar]
- Saleh, M.M.E.; Abdel-Raheem, M.A.; Ebadah, I.M.; Huda, H.E. Natural abundance of entomopathogenic fungi in fruit orchards and their virulence against Galleria mellonella larvae. Egypt. J. Biol. Pest Control 2016, 26, 203–207. [Google Scholar]
- Klingen, I.; Meadow, R.; Aandal, T. Mortality of Delia floralis, Galleria mellonella and Mamestra brassicae treated with insect pathogenic hyphomycetous fungi. J. Appl. Entomol. 2002, 126, 231–237. [Google Scholar] [CrossRef]
- Rajula, J.; Pittarate, S.; Suwannarach, N.; Kumla, J.; Ptaszynska, A.A.; Thungrabeab, M.; Mekchay, S.; Krutmuang, P. Evaluation of native entomopathogenic fungi for the control of Fall Armyworm (Spodoptera frugiperda) in Thailand: A sustainable way for eco-friendly agriculture. J. Fungi 2021, 7, 1073. [Google Scholar] [CrossRef] [PubMed]
- Alfiky, A. Screening and identification of indigenous entomopathogenic fungal isolates from agricultural farmland soils in Nile Delta, Egypt. J. Fungi 2022, 8, 54. [Google Scholar] [CrossRef]
- Oreste, M.; Bubici, G.; Poliseno, M.; Triggiani, O.; Tarasco, E. Pathogenicity of Beauveria bassiana (Bals.-Criv.) Vuill. and Metarhizium anisopliae (Metschn.) Sorokin against Galleria mellonella L. and Tenebrio molitor L. in laboratory assays. Redia 2012, 95, 43–48. [Google Scholar]
- Castrillo, L.A.; Griggs, M.H.; Liu, H.; Bauer, L.S.; Vandenberg, J.D. Assessing deposition and persistence of Beauveria bassiana GHA (Ascomycota: Hypocreales) applied for control of the emerald ash borer, Agrilus planipennis (Coleoptera: Buprestidae), in a commercial tree nursery. Biol. Control 2010, 54, 61–67. [Google Scholar] [CrossRef]
Disclaimer/Publisher’s Note: The statements, opinions and data contained in all publications are solely those of the individual author(s) and contributor(s) and not of MDPI and/or the editor(s). MDPI and/or the editor(s) disclaim responsibility for any injury to people or property resulting from any ideas, methods, instructions or products referred to in the content. |
© 2023 by the authors. Licensee MDPI, Basel, Switzerland. This article is an open access article distributed under the terms and conditions of the Creative Commons Attribution (CC BY) license (https://creativecommons.org/licenses/by/4.0/).